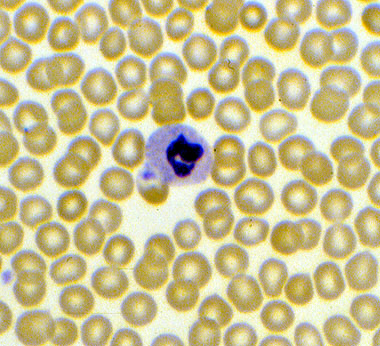

Normochromic, Normocytic red blood cells, peripheral blood smear.
Click picture to enlarge. Close window to return
The RBCs are normocytic, which indicates normal uniform size (7-8 microns). The red cells are also normochromic, which indicates normal hemoglobin content. The central pallor of a normochromic RBC occupies one - third of the red cell. A normal neutrophil is also present.